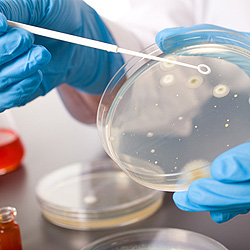

| «Выключатель» инсулина |
| Автор: http://www.zdorovieinfo.ru |
| 18 Марта 2011 |
Ученым удалось обнаружить молекулярный «выключатель», регулирующий секрецию инсулина в организме. Ученые из Университета Джонса Хопкинса в США решили выяснить, как именно поджелудочная железа секретирует инсулин и почему бета-клетки, производящие инсулин, не выполняют свою функцию у больных диабетом 2 типа. ЧИТАЙ ТАКЖЕ - Внимание ученых привлек белок снапин, который встречается как в клетках нервной системы, так и в бета-клетках поджелудочной железы. Чтобы изучит роль снапина, исследователи вывели особых мышей, у которых клетки поджелудочной железы были генетически запрограммированы на непрерывное производство этого белка. Забрав образцы клеток, ученые поместили их в чашки, куда добавили глюкозу, после чего измерили количество выработанного клетками инсулина. Оказалось, что клетки, взятые у мышей с постоянным производством снапина, производили в три раза больше этого гормона, чем клетки нормальных грызунов.
– Любопытно, что у мышей, запрограммированных на повышенное производство снапина, клетки поджелудочной не отличались большим размером, а просто производили больше инсулина. Это означает, что все клетки, секретирующие инсулин, имеют в резерве значительное количество инсулина, о котором нам даже не было известно, а также имеют «выключатель», который управляет им, – говорит автор исследования профессор Мехбуб Хуссейн (Mehboob Hussain). Чтобы убедиться, что процессом секретирования инсулина управляет именно белок снапин, ученые вырастили нормальные клетки поджелудочной железы мышей в лабораторных условиях, а затем обработали их химическим веществом, вызвавшим остановку производства белка снапина. Затем клетки поместили в глюкозу и замерили количество выработанного инсулина. Оказалось, что такие клетки производили на 80% меньше этого гормона, чем нормальные. – Эти результаты убедили нас в том, что снапин действительно является выключателем инсулина, – говорит Хуссейн. В норме бета-клетки поджелудочной вырабатывают инсулин в два этапа: непосредственно после поступления пищи и спустя примерно 15 минут после еды. Однако у людей, больных диабетом 2 типа, не происходит начального выброса инсулина. Чтобы убедиться в том, что с помощью этого механизма можно помочь таким больным, ученые взяли клетки поджелудочной у мышей, страдающих диабетом 2 типа, и заставили их вырабатывать снапин. Добавив в клетки глюкозу, исследователи обнаружили, что они действительно восстановили свою способность производить первоначальный выброс инсулина. – В опытах на животных снапин действительно смог помочь животным с диабетом 2 типа, однако еще предстоит много работы, чтобы понять, можно ли таким образом помочь и людям, подчеркивают авторы исследования, рассказавшие о нем в журнале Cell Metabolism. |






